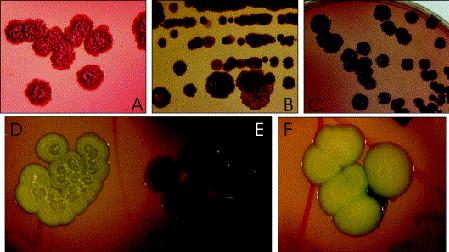

Find Amoxycillin And Clavulanic Acid
Questions and Answers
Can I drink alcohole while taking Amoxycillin Clavulanic acid 875/125mg? I had a kidney infection, which went away for a little while, then came back. I've been put on this anti-biotic, which I've been told is quite strong.
It's a five day course and on my second day, I was planning on going out and having a few drinks.
Since I've been prescribed this, I was going to limit myself to two drinks. Would this be alright?
I should also add there is nothing on the label. There was also no information sheet in the box.
Aaron D replied: "if you wanna die"
Jackie D replied: "no--alcohol stops the antibotic your infection wont heal"
Star Gazer replied: "You can, but it really reduces the effects of the amoxycillin.
Read the label, could also cause drowsiness or dizziness."
What is the correct antibiotic to cure Chlamydia? My sister has just been diagnosed with Chlamydia and her doctor has given her -(mociclav Duo Fort 875/125) amoxycillin/clavulanic acid tables to take to cure it .Is this the correct antibiotic cure for Chlamydia? Our friend is here and she is a nurse and she thinks it may be the wrong antibiotic? please help.
E x replied: "there isnt one, all antibiotics cure the same thing and they all do the same job just others are stronger than others"
Demonia replied: "Call a pharmacy. Pharmacists know more about drugs than anyone."
Ken 9 replied: "The treatment is Metronidazole (Flagyl), either 2 gram orally once or preferably 500 mg every 12 hours for 7 days. She also needs to be treated for GC with ceftriaxone IM injection x 1."
amoxyclav anybody ever used it on there pregnant dog is it safe? im not going to give you all my life story because all you get on here is critisism so just wanting to no anybody ever used this on there pregnant dog shes going on 30 days post mating and yes she is pregnant shes had a sono gram.
amoxycillin(as trihydrate)
clavulanic acid (as pottasium salt)
is it 100% safe i dont want her to abort
thanks in advance please only real comments not smart remarks.
yes its called amoxyclav and yes i got it from my vet yesterday and no i would not give my pet something that was not prescribed for her.
its just the vet had so many things out on his table and he sorta said oh this one oh no no this ones yours he didnt seem that competent(not my usuall vet) since i got a better picture on the ultrasound machine then he did.
i have extensive experience in this field but only with pigs/horses and we do not give it to a pregnant sows ect we use benza sapen ect which is penicillan.
like i said i kust wanted a simple answer i wasent going to give my life story but hey thanks anyway.
torbaynewfs replied: "OK, you are talking about CLAVAMOX, a simple antibiotic. Clearly, this was not prescribed by your vet, or you would not be asking here. What condition do you want to use this on her for????????? If she is half-way through her pregnancy, what could she need antibiotics for???? That is the question. I am not going to tell you to use it, but I can tell you I have had a pregnant bit ch on Clavamox before.
Do you have the correct dosage???????
She is NOT going to abort from Clavamox.
IF the vet prescribed it, it is fine. I really have had at least two bit ches over the years on it during a pregnancy. It is a good choice for a pregnant bit ch, yet pretty effective also. Sometimes causes diarrhea, and the chances seem to be greateer for that if pregnant, so that is something to watch for since you don't want a dehydrated, pregnant girl.
When it doubt, though, call the vet and ask!!!"
MANDYLBH replied: "if you have any concerns about the medicine he gave for her, call him and discuss it with him. What illness did he give it to her for?
Call and talk to the vet. It is an antibiotic.
here is a site about the drug. Go check it out."
Find More Websites
REVIEW: USE OF AMOXYCILLIN + CLAVULANIC ACID COMBINATION IN ...
Amoxycillin and clavulanic acid combination is used in veterinary medicine since ... decreased susceptibility of human pathogens to amoxycillin and clavulanic acid ...
Comparative activities of amoxycillin, amoxycillin/clavulanic ...
The activity of amoxycillin, amoxycillin/clavulanic acid and two tetracycline ... Amoxycillin and clavulanic acid, alone and in combination, reduced the incidence ...
Pharmacokinetics of amoxycillin and clavulanic acid in ...
Pharmacokinetics of amoxycillin and clavulanic acid in haemodialysis patients ... was lower than that in normal subjects for both amoxycillin and clavulanic acid. ...
SPIMACO - Products
Each tablets contains 250mg amoxycillin and 125 mg clavulanic acid. ... Each 25mg KLAVOX provides 20mg amoxycillin and 5mg clavulanic acid. ...
AUGMENTINÛ 375 tablets; AUGMENTINÛ 625 tablets; AUGMENTINÛ BD ...
... the 2 parts amoxycillin and 1 part clavulanic acid AUGMENTIN 375 tablet, taken ... 64,9% of amoxycillin and 37,5% of clavulanic acid are excreted unchanged in the ...
Clavulanic acid (Beta-lactamase inhibitor) (Chemical Page)
Clavulanic Acid. INFORMATION AVAILABLE. GENERAL CHEMICAL INFORMATION ... that the presence of clavulanic acid affects the pharmacokinetics of amoxycillin. ...
SPIMACO - Products
Each tablet contains 250 mg amoxycillin and 125 mg clavulanic acid. ... Each 25 mg Augmentin provides 20 mg amoxycillin and 5 mg clavulanic acid. ...
Penetration of amoxycillin/clavulanic acid into bronchial ...
The concentrations of clavulanic acid and amoxycillin were determined by high ... CONCLUSIONS--Amoxycillin and clavulanic acid are concentrated in bronchial ...
Pharmacy - Store Items
Chem mart(R) Amoxycillin and Clavulanic Acid 875mg/125mg ... Do not take amoxycillin and clavulanic acid if you have previously experienced ...
GenRx Amoxycillin and Clavulanic Acid 875 mg/125 mg Tablets
GenRx Amoxycillin and Clavulanic Acid 875 mg/125 mg TabletsPublished by MIMS/myDr October 2009 ... amoxycillin and clavulanic acid. tablets for another reason. ...
Amoxycillin and clavulanic acid combination is used in veterinary medicine since ... decreased susceptibility of human pathogens to amoxycillin and clavulanic acid ...
Comparative activities of amoxycillin, amoxycillin/clavulanic ...
The activity of amoxycillin, amoxycillin/clavulanic acid and two tetracycline ... Amoxycillin and clavulanic acid, alone and in combination, reduced the incidence ...
Pharmacokinetics of amoxycillin and clavulanic acid in ...
Pharmacokinetics of amoxycillin and clavulanic acid in haemodialysis patients ... was lower than that in normal subjects for both amoxycillin and clavulanic acid. ...
SPIMACO - Products
Each tablets contains 250mg amoxycillin and 125 mg clavulanic acid. ... Each 25mg KLAVOX provides 20mg amoxycillin and 5mg clavulanic acid. ...
AUGMENTINÛ 375 tablets; AUGMENTINÛ 625 tablets; AUGMENTINÛ BD ...
... the 2 parts amoxycillin and 1 part clavulanic acid AUGMENTIN 375 tablet, taken ... 64,9% of amoxycillin and 37,5% of clavulanic acid are excreted unchanged in the ...
Clavulanic acid (Beta-lactamase inhibitor) (Chemical Page)
Clavulanic Acid. INFORMATION AVAILABLE. GENERAL CHEMICAL INFORMATION ... that the presence of clavulanic acid affects the pharmacokinetics of amoxycillin. ...
SPIMACO - Products
Each tablet contains 250 mg amoxycillin and 125 mg clavulanic acid. ... Each 25 mg Augmentin provides 20 mg amoxycillin and 5 mg clavulanic acid. ...
Penetration of amoxycillin/clavulanic acid into bronchial ...
The concentrations of clavulanic acid and amoxycillin were determined by high ... CONCLUSIONS--Amoxycillin and clavulanic acid are concentrated in bronchial ...
Pharmacy - Store Items
Chem mart(R) Amoxycillin and Clavulanic Acid 875mg/125mg ... Do not take amoxycillin and clavulanic acid if you have previously experienced ...
GenRx Amoxycillin and Clavulanic Acid 875 mg/125 mg Tablets
GenRx Amoxycillin and Clavulanic Acid 875 mg/125 mg TabletsPublished by MIMS/myDr October 2009 ... amoxycillin and clavulanic acid. tablets for another reason. ...
Popular Tags
amoxycillin and clavulanic acid, newson cr 2032 lithium battery, lotensin and enalapril in animals, apc alis ciales recall tadalafil, cdc malaria india doxycycline, aurobindo simvastatin images, zoloft drug scheduling, keflex dosages, side effects of thyroxine in dogs, testosterone replacement therapy bad woman, but cialis online, masturbation and testosterone levels, stationery brands, simple interest loan calculator, small notebook computers reviews, golden corral coupons, street racing video crashes, brazil government system, switching from effexor xr to lexapro, dsl service providers in my area
Amoxycillin And Clavulanic Acid © 2009





